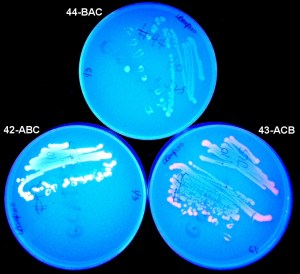
GCAT_colorsx

This week my students will be trying out the “bacterial computer.” Originally constructed by biology students for the GCAT consortium, the bacterial computer has a plasmid of three flippable segments, two of which encode fluorescent proteins (red and green). The DNA segments get flipped by a protein called Hin Recombinase, originally invented by Salmonella enterica to flip its genes for expressing different coat proteins that fool the human immune system. In the plates above, the upper plate has both plasmids flipped off; the lower left, both green and red on (makes yellow); and the right, only red. But continued flipping can generat plasmids that fluoresce red with a bit of green, or vice versa, and other unexplained things. Biology is always a bit more complicated.
The plasmid can solve a Hamiltonian problem by ending up fluorescing yellow. This may not sound like much, but it reminds me of the plastic computer I built in the 60s that could only count to seven. Who knows what kind of computer our children will have on their desks–or whether they’ll have desks at all.
3 responses to “The Bacterial Computer”
Joan, your postings always make me hear that roaring over my shoulder, the approach of the future shock tsunami so few of us can even comprehend–speaking of which, Man!, do you have wicked hyperlinks!
regards,
one bio-computer to another…
There was a lot of interest in using biology to do computing a while back, although this seems to have abated. I was most impressed with Shapiro’s work about 8 years ago that was published in Nature. I think he licensed the technology but I haven’t followed up on what happened.
The critique with NP hard problems being done in biology is that the demonstrations work with small numbers of nodes, but to do real problems requires impractically vast amounts of material, simply because they are doing brute force search.
However I do think there is a tremendous role for them to play in doing the sorts of computations that are needed in diagnostic devices that read the states of gene expression or metabolic indicators.
I think there is a limited set of problems for which DNA theoretically outperforms any supercomputer.
The Hamiltonian is the one we always hear mentioned.